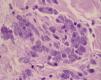

Describimos el caso de un paciente varón de 44 años, homosexual, infectado por el virus de la inmunodeficiencia humana (VIH) y diagnosticado de leishmaniasis visceral. Clínicamente presentaba unos nódulos en el dorso de las manos. El estudio histológico de uno de ellos mostraba granulomas necrobióticos en empalizada y abundantes amastigotes de Leishmania dentro de los histiocitos y extracelularmente en la proximidad.
Los cultivos tisulares y de sangre periférica fueron positivos para Leishmania infantum, con el análisis isoenzimático zymodema 24. Una biopsia de piel sana no reveló la presencia de Leishmania. El diagnóstico fue de nodulosis reumatoide con Leishmania, y se inició tratamiento con anfotericina liposomal intravenosa con leve mejoría.
Consideramos que la presencia del parásito en los nódulos fue producida por la diseminación durante la leishmaniasis visceral, en el contexto de un paciente inmunosuprimido, como en una infección por el VIH, y no tiene un papel etiológico en su origen. Es decir, no pensamos que los parásitos hayan producido los nódulos. Presentamos el primer caso de asociación entre leishmania y nodulosis reumatoide.
We describe the case of a 44-year-old homosexual man diagnosed with HIV infection and visceral leishmaniasis. He presented nodules on the dorsum of the hands. Histological study of one of the nodules revealed necrobiotic palisading granulomas with abundant Leishmania amastigotes within the histiocytes and in the adjacent extracellular space. Tissue and peripheral blood cultures were positive for Leishmania infantum, zymodeme MON-24. A biopsy of healthy skin did not reveal the presence of Leishmania. A diagnosis of rheumatoid nodulosis with Leishmania was made and treatment was started with intravenous liposomal amphotericin, leading to slight improvement. We believe that the presence of the parasite within the nodules was the result of its dissemination during visceral leishmaniasis in an immunocompromised patient with HIV infection, and that the Leishmania did not have an etiological role in the appearance of the nodules. We present the first case of the association between Leishmania and rheumatoid nodulosis.
En 1985 De la Loma et al describieron el primer caso de leishmaniasis asociada con infección por el virus de la inmunodeficiencia humana (VIH)1. Desde entonces han sido publicados nuevos casos de esta asociación, fundamentalmente en países del entorno Mediterráneo. En España se estima que entre el 1 y el 5% de los pacientes con el síndrome de la inmunodeficiencia adquirida (sida) están infectados, siendo la adicción a drogas por vía parenteral un factor de riesgo en más del 85% de los casos2,3. A pesar del tratamiento correcto, un porcentaje de estos pacientes puede presentar un curso más agresivo y crónico, con manifestaciones atípicas, más graves, mayor tendencia a la recidiva y peor respuesta al tratamiento.
El término «nodulosis reumatoide» (NR) fue creado por Ginsberg et al en 19754. Aunque la definición varía según los diferentes autores, es considerada por la mayoría como una variante particular de artritis reumatoide asociada con reumatismo palindrómico, nódulos reumatoides subcutáneos con histología confirmatoria, con o sin mínimo daño articular y/u otras manifestaciones sistémicas, y en general un curso clínico benigno. El factor reumatoide positivo y los quistes óseos subcondrales radiológicos son comunes, pero su ausencia no descartaría el diagnóstico, principalmente al inicio. Aunque la NR puede cumplir los criterios de la Asociacion Reumatológica Americana (ARA) para un diagnóstico de artritis reumatoide, su curso clínico es diferente4.
Nosotros presentamos un paciente positivo para el VIH, diagnosticado de leishmaniasis visceral y NR, que presentaba Leishmania entre los granulomas necrobióticos en empalizada de varios nódulos en el dorso de las manos. Destacamos esta asociación, no descrita previamente en la literatura, y discutimos el papel patogénico del parásito en el desarrollo de las lesiones cutáneas.
Caso clínicoSe trata de un paciente varón de 44 años, homosexual, dueño de 10 perros, positivo para el VIH desde 1993, en tratamiento desde entonces con terapia antirretroviral. En julio de 2000 había sido diagnosticado de varios episodios de candidiasis oroesofágica, sífilis y leishmaniasis visceral. Se pautó tratamiento con antimoniato de meglumina intramuscular hasta enero de 2001, con una aparente curación completa.
En julio de 2002 ingresó en el hospital por una neumonía por Legionella. Se encontraba en tratamiento con didanosina, estavudina, lamivudina, nevirapina y trimetropim/sulfametoxazol. El paciente estaba febril con escalofríos, respiración disneica, tos productiva y dolor pleurítico subesternal. Además presentaba astenia, postración y pérdida de peso. Refería la aparición hacía 7 meses de unos nódulos asintomáticos en el dorso de las manos, sin artralgias ni brotes de rigidez articular. En la exploración se observaban, junto con los signos de malnutrición severa, nódulos de coloración similar a piel sana, bien delimitados, indurados, en el dorso de ambas manos, fundamentalmente en las áreas periarticulares (interfalángicas proximales y distales) (fig. 1). El resto de la exploración física fue normal.
El estudio histopatológico de dos de las lesiones mostraba hallazgos similares, consistentes al nivel de la dermis en una lesión nodular, caracterizados por una extensa necrobiosis de colágeno, asociada a un infiltrado inflamatorio fundamentalmente por histiocitos, que en la mayoría de los casos se disponían en empalizada. Se detectaban múltiples cuerpos de Leishmania, tanto en el interior de los histiocitos como libres alrededor del material necrobiótico. También se identificaban Leishmanias, aunque en menor cuantía, en la dermis sana adyacente, y en número muy escaso en los queratinocitos basales. No se detectaron depósitos de mucina (figs. 2 y 3). La biopsia de piel sana no reveló la presencia de Leishmanias. El paciente rechazó la realización de una biopsia de medula ósea. El cultivo de la lesión nodular y de sangre periférica fue positivo para Leishmania infantum, con el análisis isoenzimático zimodema 24.
El cultivo de piel sana fue negativo. La identificación de Leishmania por reacción en cadena de la polimerasa fue positiva en la piel lesional y en sangre, y negativa en la piel sana.
En la analítica destacaba anemia grave (hemoglobina 7g/dl), leucopenia (3,5×109) y trombocitopenia (100×109); volumen de sedimentación globular de 123mm, gamma glutamil transpeptidasa (54UI/l); proteína C reactiva (0,9mg/dl), factor reumatoide (FR) (95,8UI/ml). Además asociaba hipergammaglobulinemia (37,8%), anticuerpos antinucleares positivos a título 1/80 con SS-A/Ro, SS-B/La, Sm, RNP y Jo-1 negativos. La carga viral para el VIH era de 351.000 copias/ml, con un recuento de linfocitos CD4 de 40/mm3 y CD4/CD8 de 0,23. El resto de los parámetros fueron normales. La serología de Leishmania (IFI) fue positiva a título IgG 1/640.
La ecografía abdominal mostró hepatomegalia homogénea y bazo marcadamente aumentado de tamaño (18cm). Las radiografías de manos y pies revelaron un aumento de partes blandas en las manos, correspondientes a los nódulos, sin otros hallazgos relevantes. El informe de Reumatología fue de NR. Junto con el tratamiento antibiótico para la neumonía se inicio tratamiento intravenoso con anfotericina B liposomal (3mg/kg/48h). El cuadro sistémico se resolvió, las lesiones cutáneas mejoraron parcialmente y el paciente fue dado de alta con revisiones posteriores.
Tras la persistencia de las lesiones en las manos, después de 7 meses de tratamiento, se realizó una nueva biopsia con hallazgos similares, aunque con menor cantidad de parásitos. Actualmente recibe dosis de mantenimiento con anfotericina liposomal quincenal.
DiscusiónEl compromiso cutáneo en la leishmaniasis visceral (LV) asociada al VIH no es frecuente, siendo en alguna ocasión el primer signo que precede a la afectación visceral. Destaca la gran variabilidad en su presentación clínica y entre las más frecuentes se incluyen las máculas, pápulas, placas, nódulos y úlceras3. También puede presentarse con formas clínicas atípicas como la eritrodérmica5, la psoriasiforme6 o las lesiones similares a dermatomiositis7.
No obstante, se han descrito casos en pacientes con LV y sida, donde el hallazgo de Leishmanias ha sido casual, al realizar biopsias para estudiar otras patologías cutáneas, lo que sugiere que su presencia es un hallazgo incidental y no la causa de la enfermedad. De hecho, se ha demostrado el parásito coincidiendo con lesiones del sarcoma de Kaposi8, en coinfección con el virus del herpes simple y herpes zoster9,10, en la angiomatosis bacilar11, en el síndrome de Reiter11, en el dermatofibroma11,12, en la psoriasis11, en coinfección con el criptococo11 y en aftas bucales11,13.
En algunos casos la detección de Leishmanias en estas lesiones ha llevado al diagnóstico de una insospechada LV11. Además, se pueden observar amastigotes en el estudio histopatológico de la piel sana de los casos de LV e inmumosupresión, especialmente sida6,14.
Nuestro paciente fue diagnosticado de LV asociada a infección por el VIH y una inmunodeficiencia profunda (sida estadio C3). Por otro lado, destacaba la presencia de unos nódulos de meses de evolución, situados en el dorso de las manos, principalmente a nivel periarticular. Basándonos en la morfología clínica de los nódulos, la histología de los mismos mostrando granulomas necrobióticos en empalizada, una analítica con elevación del factor reumatoide en ausencia de signos y síntomas de la artritis reumatoide, todo ello sugiere como diagnóstico más probable una NR, que fue confirmada por el Servicio de Reumatología.
Aunque se han descrito en la literatura nódulos como presentación clínica de LV creemos que en nuestro caso la presencia de amastigotes en los nódulos no tiene un papel patogénico en la aparición de las lesiones. La correlación clinicopatológica de los nódulos, la escasez de Leishmania en la dermis sana adyacente a los granulomas y la falta de respuesta al tratamiento de las lesiones cutáneas apoya la hipótesis anterior. La presencia del parásito en procesos cutáneos con los que no está relacionado se explicaría por la diseminación masiva del mismo ante un sistema inmunitario totalmente ineficaz, como en la infección por el VIH. La gran vascularización y la presencia abundante de histiocitos (reservorio de Leishmania) podría favorecer la invasión de estas lesiones. Actualmente se desconoce si los parásitos pueden influir en la gravedad o cronicidad de los nódulos de la NR.
No hemos encontrado descrita en la literatura una asociación entre Leishmania y NR. Existe un caso publicado de un paciente VIH negativo, diagnosticado de artritis reumatoide desde hacía más de 10 años, en tratamiento con metotrexato y prednisona, que presentaba simultáneamente nódulos reumatoides y Leishmania cutánea. En uno de estos nódulos los parásitos se localizaban intra y extracelularmente. Los autores sugieren que los macrófagos en los nódulos representan un reservorio seguro para los parásitos15.
Nosotros queremos resaltar, en nuestro caso, la presencia de cuerpos de Leishmania dentro de los queratinocitos de la epidermis. Se ha descrito de forma ocasional el hallazgo de parásitos dentro de la células epiteliales de las glándulas ecrinas y dentro de los ductos ecrinos14, y sólo excepcionalmente invaden los queratinocitos6,16. Estos hallazgos sugieren la posibilidad de la eliminación del parásito a través de los queratinocitos epidérmicos16.
Como conclusión, presentamos el primer caso de la asociación entre Leishmania y NR. Creemos que la NR debería ser añadida a la lista de enfermedades donde el hallazgo de Leishmanias se trate de una mera presencia pasiva en un área inflamatoria, donde determinados factores o estímulos locales favorecerían su acumulación.